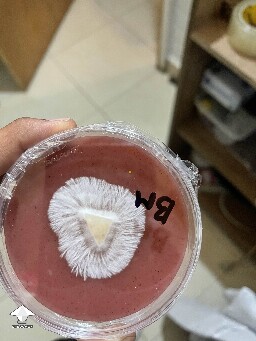
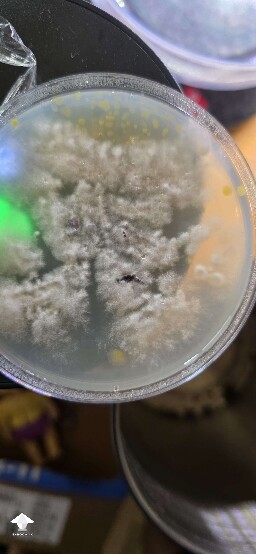

Contamination gallery on Shroomok
Photo gallery of contam identification in mushroom cultivation. Growers' concerns about whether mycelium is contaminated or not. Mold, bacteria, yeast, virus, abnormal growth, no growth at all. Some cases are not contaminants, but cultivators are worried
Shroomok's choice on Amazon

Load more photos